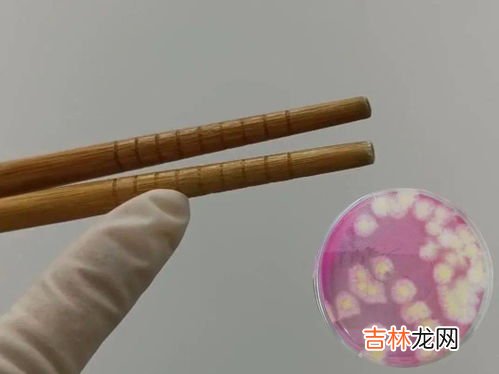

选材质
木材也分很多种,有铁黎木,有红檀木,竹子等,其中木料有好有差 。有很多使用普通木材制成的筷子也称是铁木制成的,这时我们一定要注意分辨 。一般铁木的纹理比较细,表材为浅黄褐色,内部为浅红褐色 。如果不是这样就可能是上过色的假铁木 。选红木筷子时,也要看它是否是上色的其他木料,内外的颜色应该一致 。竹筷子也是不错的选择,因为竹筷子无毒无害,还容易刷漆上色 。我们选筷子尽量选择天然木料制作的,不要选择上油、涂漆的 。
日常使用筷子有什么注意事项
筷子变色可能变质 。
筷子用久了,颜色会发生或深或浅的变化,主因是细菌长期堆积导致的 。每天应仔细观察筷子,一旦发现表面有斑点 , 特别是霉斑 , 说明已发霉变质,应赶紧更换 。
筷子开裂藏细菌 。
经常使用、搓洗的过程会给筷子留下深深浅浅的伤痕,使筷子表面变得粗糙 , 甚至开裂变形 , 极易藏污纳垢,成为大肠杆菌、幽门螺杆菌等有害菌的温床 。藏在筷子细小凹槽里的微生物和清洁剂 , 还可能侵犯人体呼吸道,引发呼吸系统疾病 。如果筷子出现弯曲、变形 , 看上去很潮湿或闻起来有明显酸味,都是受污染或过期的标志,不可继续使用 。
清洗随便细菌长得快 。
很多人在家洗筷子时很“豪爽”,近五成人都选择在水龙头下冲洗,搓得哗哗响,然后往筷子筒里一插就算洗好了 。董金狮表示,这种洗法,筷子很可能没彻底洗净,细菌很快就会滋生 。清洗筷子时,首先要把筷子表面冲净,再用洗洁精仔细搓洗筷子,洗完后沥干水渍才能放入筷子筒 。
文章插图
文章插图
3、新筷子第一次用要怎么处理?新买筷子,需要彻底清洗处理 。
专家提醒,筷子在生产和运输过程中易沾染病毒和细菌以及某些化学物质 。新买的筷子可以先用自来水清洗干净,第二次再用洗洁精来洗,最后放到锅里,沸水煮半小时就可以了 。
平时清洗筷子要彻底,先把筷子表面冲净,再用洗洁精仔细搓洗筷子,然后放入消毒碗柜中消毒、烘干,也可冲洗并沥干水后,再放进筷子盒 。
扩展资料:
专家建议:每周将筷子放入沸水中煮半小时后,放置在空气中晾晒干燥再使用,这样可以达到消毒的作用 , 且能有效、便捷地清除筷子内的霉菌 。如果筷子上出现非竹子或木头本色的斑点,表示该筷子很可能已经发霉变质,不可继续使用;筷子显得潮湿或出现弯曲、变形,则表示已受潮或搁置时间太长,很可能已经过了保质期;闻一闻,如果有明显的酸味 , 都是受污染或过期的标志,不可继续使用 。
参考资料:人民网-筷子多长时间换更健康?筷子使用6大要点
新买的筷子,牢记不可用水煮!只需这样处理一次,用一年持久如新

文章插图
文章插图
4、新买的筷子怎样处理才可以用新筷子表面都会覆盖一层薄蜡 , 一来可防止霉变,二来可防止开裂 。使用前需用洗洁精洗去薄蜡才可用 。一共四个步骤 , 下面是详细操作:
操作/步骤
1
滴洗洁精
将筷子泡在温水中,滴入几滴洗洁精,洗去表面薄蜡 。
2
煮筷子
煮锅中,加水没过筷子,加盐、白醋适量,大火开煮,水开后再煮三分钟,关火捞出 。
3
擦去水分
用干毛巾擦去水分,将筷子彻底晾干,家有消毒柜或者微波炉的可放进去烘干 。
经验总结扩展阅读
- 新鲜羊肚菌怎么保存得比较久,鲜羊肚菌可以冷冻保存吗
- 新鲜花椒如何长期保鲜,花椒怎样保存才新鲜不跑味
- 新型智慧城市五大发展目标,新型智慧城市五大特征是什么?
- 用清水洗筷子等于吃细菌,每天用清水洗筷子可以洗掉细菌吗?正确的做法是什么?
- 穿搭 70岁胡因梦亲身示范:女人上了年纪留短发、穿新中式,老了也优雅
- 创新的原则,创新关键原则的5个要做、3个不要做和3个条件
- 鸡蛋打出来散了是坏了吗,鸡蛋打出来,蛋黄散开是不是鸡蛋不新鲜
- 彩妆 杨幂朵拉头新发型释出,手捧钞票凹造型又美又帅,眼神超A
- 苹果手机的id怎么重新设置,苹果手机怎么重新设置id账号
- 吃光明好韵有哪些反应,光明新零售好韵功效如何,有哪些功效啊?